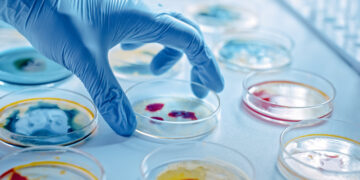
Can We Use Microbes to Colonize Space?

As the Apollo 13 disaster happened, only nine months after this event, NASA decided to try again for Apollo 14. Three astronauts were selected for this mission – Edgar Mitchell, Alan Shepard, and Stuart A. Roosa. Alan Shepard was already known internationally for being the first American, second human overall, in space in 1961. Alan Shepard soaked his urine owing to delays in the launch and no bathroom facility on board. Mitchell and Roosa, both were highly qualified engineers and pilots.
In 1953, a few years before this, Roosa got a summer job as a smokejumper for the United States Forest Service. Roosa got this job when it was announced that he would be a member of the Apollo 14 crew.
Ed Cliff was the Chief of the Forest Service who called Roosa and asked if he could take a steel canister filled with 500 seeds with him aboard Apollo 14. The query consisted of Douglas fir, sequoia, sycamore, sweetgum, and loblolly pine. Stan Krugman, who worked at the US Forest Service and was acquitted in charge of selecting the seeds, noted, “I took redwoods because they were famous, and the others as they would grow perfectly well in the United States’ many parts. These seeds came from two Forest Service genetics institutes.
Besides being reputed in public, the wish was to use those seeds to observe how timber could grow back on Earth being exposed to space travel. Stan Krugman said, “The scientists wanted to find out what could appear to these seeds if they took a ride to the Moon. Would they germinate? Would the bushes look regular as they may be at the Earth?
Apollo 14
As each astronaut of the Apollo 14 was allowed to hold a Personal Preference Kit with them and the seeds were otherwise innocuous, NASA authorities gave the idea their blessing, and Roosa eventually agreed to take them along with him. The seeds orbited the Moon 34 times, within the command module Kitty Hawk at the same time Shepard was at the lunar floor taking chip photographs with a couple of his own items.
On 9th Feb 1971, Apollo 14 went down in the South Pacific Ocean with neither the danger nor drama of Apollo 13. The seed-holding steel canister, unfortunately, burst open when exposed to a close to vacuum environment at some stage in the decontamination process again on Earth. As a result, all the seeds scattered.
One of the second-generation Moon bushes became planted in 2005 on the Arlington National Cemetery near Roosa’s grave, who died approximately a decade earlier. As of now, there are only 12 persons to be alive today, having traveled to the Moon and all of whom are over the age of 82.